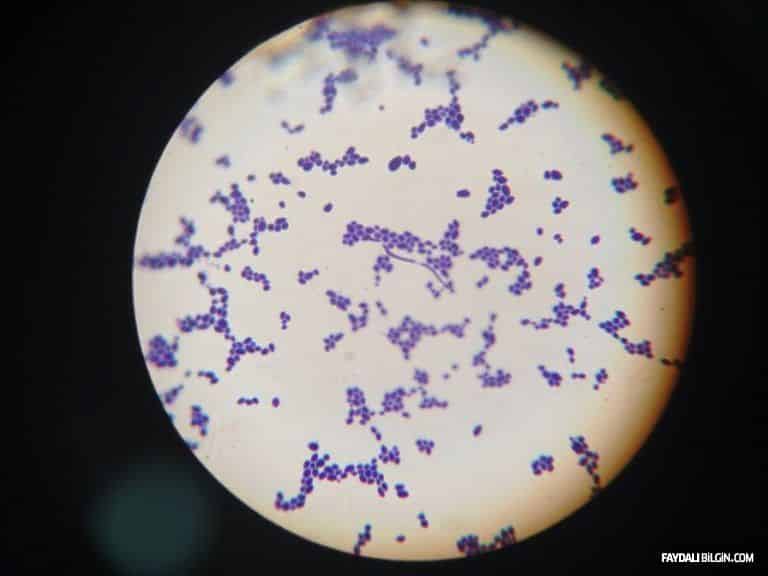
Mantar Enfeksiyonu

Diyabet Belirtileri Maddeler Halinde!
Diyabet, doğru tedavi edilmediği takdirde koroner arter hastalığı (KAH) ve inme gibi ciddi komplikasyonlara neden olabilen ciddi bir durumdur. Diyabet belirtilerini öğrenerek erken tanı konması için doktorunuza başvurabilirsiniz.

İnsanların pek çoğu, Diyabet (şeker hastalığı) olduğunu bile bilmiyorlar. Diyabet Belirtilerini gözardı ederseniz, riskler o kadar yüksek olur. Diyabet kolaylıkla tespit edilebilir ve kontrol altında tutulabilir. Hatta belki belirtileri erkenden fark ederek ilerlemesini durdurabilirsiniz. Aşağıdaki Diyabet Belirtilerinden herhangi birini yaşadıysanız, doktorunuza başvurmayı ve test yaptırmayı düşünmelisiniz.
Sık idrara çıkma (Poliüri)

Çok sık idrara çıkma (poliüri) hissi devamlı mevcuttur. Bunun sebebi ise, kan şekeri yükseldiğinde böbrekler emme işlevini yerini getiremediklerinde, fazla şekeri atmak için uğraşırlar. Çoğunlukla kan glukozu 180 mg a eriştiğinde idrar aracılığı ile glukoz atılmaya başlar (glikozüri). Çok uzun yıllardır şeker hastalığı olan kişilerde bu oran çok daha fazla yükselmeden idrarda glukoz çıkmayabilir.
İdrarla vücuttan çıkarılan şeker ile birlikle suyun da atılımını da sağlar. Bu sayede ortaya çıkan sıvı kaybı ile aşırı susama (polidipsi) duygusu ortaya çıkar. Bu belirti genellikle hastalar tarafından yalnızca ağız kuruluğu olarak ortaya çıkar.
Artan susama (Polidipsi)

Kan dolaşımındaki aşırı şekeri böbrekler vücuttan atmak için daha fazla idrar üretecektir. Vücudunuz idrar üretimini artırdıkça ve daha sık idrara çıktıkça, sıvıları kaybedersiniz ve susuz hale gelirsiniz. Sonuç olarak, vücudunuz sıvı kaybını telafi etmeye çalışacaktır. Bu nedenle su içme ihtiyacı hissedeceksiniz.
Artan Açlık (Polidipsia)

Diyabetle vücudunuz insüline dirençli hale gelir. Kandaki yüksek glikoz seviyeleri vücudunuzun yüksek karbonhidratlı yiyecekleri yedikten sonra çok fazla insülin üretmesini sağlar ve glikoz seviyeleri anında düşer. Sonuç olarak, titrekleşiyorsunuz ve şeker ya da karbonhidratlar için can atıyorsunuz.
Kandaki şekerin hücre içine girmesi için yeterli insülin bulunmadığından kaslar ve organlarda enerji açığı meydana gelir. Bu durum açlığı tetikler. Yemek yedikten hemen sonra bile açlık devam eder. İnsülin kullanılmadan, yiyeceklerin içindeki şekerler, adeta enerji fakiri olan vücut dokularını doyuramaz.
Ağız Kuruluğu (Xerostomia)

Hem tip 1 hem de tip 2 diyabetin en yaygın semptomlarından biri kuru ağızdır ve yüksek şeker seviyelerinin kandaki etkilerinin bir sonucu olabilir. Yüksek kan şekeri seviyeleri sık idrara çıkmaya neden olur, zira böbrekler şeker fazlalığını ortadan kaldırmak için daha fazla idrar oluştururlar. Artmış idrarın bir sonucu olarak, vücut sıvıyı kaybeder ve susuz hale gelir. Sıvıların kaybını telafi etmek için yeterince su içmezseniz, ağzınız kuru olur.
Baş Ağrısı

Diyabetli kişilerde, kan şekeri düzeylerindeki değişimlere bağlı olarak baş ağrıları meydana gelir. Kan şekeri denemenizdeki daha fazla iniş ve çıkışlar, daha çok başınız ağrır. Baş ağrısı, beyindeki kan damarlarının, hormon değişikliklerine tepki olarak ortaya çıkar.
Bulanık Görüş

Yüksek kan şekeri seviyelerinin bir başka sonucu da, gözünüzün lensinde glikozun oluşmasına neden olmasıdır. Sonuç olarak, gözünüzdeki mercekler şişecek ve görüşünüz bozulacak. İyi haber, kan şekeri seviyeleriniz normal seviyelere ulaştığında semptomun geri dönüşlü olması.
Mantar Enfeksiyonu
Kan dolaşımındaki yüksek seviyelerdeki şeker, maya ve enfeksiyona neden olan bakteriler için bir üreme alanı oluşturur. Tekrarlayan enfeksiyonlar diyabetin mükemmel göstergesidir. Öyleyse bu sizin durumunuzsa ve teşhis edilmediyse, doktorunuza diyabet testi yaptırın.
İyileşmeyen Kesikler ve Morluklar
Organizmadaki şeker seviyeleri sürekli yüksek olduğunda, kan damarlarını daraltır, atardamarları sertleştirir ve kırmızı kan hücrelerinin işlevini azaltır. Kan damarları daraltılırsa, kan ve oksijen yaraya ulaşamayacak ve iyileşmesi için yeterli besin ve oksijeni sağlayamayacaktır. Böylece vücudunuzun iyileştirici etkileri daha yavaş ve daha az etkili olacaktır.
Ellerde Uyuşma ve Karıncalanma

Uzun bir süre boyunca kan dolaşımındaki yüksek seviyelerde glikoz seviyeleri sinirlere zarar verebilir. Bu diyabetik nöropati denir ve bu diyabetin en üzücü uyarı işareti. Diyabetik nöropatiden muzdarip insanlar, ellerde ve ayaklarda karıncalanma, kasık kramp veya güçsüzlük, çoğunlukla geceleri oluşan ağrı ve koordinasyonla ilgili zorluklar yaşarlar.
Cinsel İşlev Bozukluğu

Yüksek şeker seviyesi, hem erkeklerde hem de kadınlarda damar ve sinir hasarlarına bağlı cinsel işlev bozukluğuna neden olur. Diyabetli erkeklerin yaklaşık% 35 ila 75’i erektil disfonksiyon yaşayacaktır. Ereksiyon elde etmek için sadece erkeklerin cinsel olarak uyarılması gerekmez, aynı zamanda sağlıklı sinirlere ve kan damarlarına da ihtiyaç duyarlar. Kadınlar cinsel ilişkide rahatsızlık yaratabilecek vajinal kuruluk yaşayabilirler ve genital bölgede duyu kaybına bağlı olarak orgazma ulaşma güçlüğü çekebilirler.
Plansız Kilo Kaybı

Bu tip 1 diyabetli insanlara olur. Yüksek kan şekeri seviyelerinin bir sonucu olarak vücudunuzda meydana gelen iki şeyin bir ürünüdür. İlk olarak, kaybettiğiniz kilonun bir kısmı aşırı idrara çıkma nedeniyle kaybettiğiniz su yüzünden olur. Ve ikincisi, vücudunuz daha az insülin ürettikçe, enerji olarak kullanılmak üzere kandan ve vücuttan glikoz alamayacaktır. Sonuç olarak, vücudunuz enerji elde etmek için yağ ve kas yakmaya başlayacaktır.
Boyundaki Siyah Lekeler (Akantoz Nigrikans)

Kandaki yüksek düzeydeki insülin, deri hücrelerini hızla çoğaltır. Boynunuzda, kollarınızda, dirseklerin içinde ve dizlerin arkasında koyu renkli lekeler olarak görünür.
Ağızda Aseton Kokusu

Vücudunuz insülin yapamadığı zaman, vücudunuzdaki hücreler ihtiyaç duydukları yakıtı glikoz formunda almazlar. Sonuç olarak, vücudunuz yağ yakmaya başlar ve kanınızda ve idrarınızda biriken ketonları üretir. Ketonlar güvenli olmayan bir seviyeye ulaştığında, diyabetik ketoasidoz veya (DKA) olarak adlandırılan ciddi bir durum geliştirme riskiniz vardır. Diyabetik ketoasidozun belirtileri arasında hastaların nefesinde belirgin bir aseton kokusunun olması, Kussmaul solunumu adı verilen çok hızlı ve derin soluma, poliüri, mide bulantısı, kusma ve karın ağrısı, çeşitli tiplerde mental (saldırganlık, mani, zihin karışıklığı gibi) bozuklular sayılabilir. Şiddetli diyabetik ketoasidoz vakalarında tablo komaya doğru ilerleyebilir ve ölümle sonuçlanır. Diyabetik ketoasidoz tıbbi bir acil durumdur ve hastaların derhal hastaneye kaldırılmaları gerekir.
Hızlı Nefes

Diyabetiniz varsa ve hızlı ve zor nefes alıp veriyorsanız, ağızda aseton kokusu, bulantı kusma ve mide ağrısı gibi diğer belirtilerle birlikte, diyabetik ketoasidoz varlığındasınız ve hızlı bir şekilde tıbbi yardım almalısınız! Diyabetik asidoz, hastaneye yatmayı ve sıvı ve insülin ile tedavi gerektiren hayatı tehdit eden bir durumdur.
Yüksek Tansiyon

Kontrolsüz diyabet, yüksek tansiyona yol açabilir ve böbrek hastalığı, dolaşım problemleri, göz hastalığı, kalp hastalığı ve inme gibi başka bir dizi sağlık riskine neden olabilir.
Yorgunluk

Yemek yediğinizde, vücudunuz insülin yardımıyla glikozu gıdaya dönüştürür. Glikoz daha sonra enerji elde etmek için hücreleriniz tarafından kullanılır. Vücudunuz yeterli insülin yapmıyorsa veya insüline dirençli iseniz, glikoz enerji üretmek için hücrelere giremeyecektir. Sonuç olarak, normalden daha yorgun hissedeceksiniz.
Ruh Hali

Hiç açıklanamayan bir ruh hali salınımı yaşadınız mı? “Evet” cevabını verdiyseniz, doktorunuzla konuşmalı ve diyabet testi yapmalısınız. Beyniniz düşüncelerinizin ve duygularınızın merkezidir; İhtiyacınız olan her şeyi size sağlayacak motor. Fakat arabanızın motoru gibi, işini yapmak için yakıt ihtiyacı var. Beyin için yakıt glikozdur. Çok az veya çok fazla glikoz alırsa ruh halinizi etkileyebilir.
Yorumlar
Yorumlar moderasyonludur, onay sonrası yayınlanır.
Yorum Yap
E-posta adresiniz yayınlanmaz. Tüm alanları doldurun.
Bunlar Da İlgini Çekebilir

Vücudunuzu Yeniden Canlandırın: Evde Hazırlayabileceğiniz 5 Etkili Detoks Tarifi
Bu yazımızda, uzman tavsiyeleriyle hazırlanmış, kolayca temin edebileceğiniz malzemelerle evde uygulayabileceğiniz 5 ...

Cinsel isteksizlik nedir?
Cinsel isteksizlik, hem bireylerin hem de çiftlerin yaşam kalitesini etkileyen önemli bir konudur. Bu makalede cinsel...

Kalp Sağlığı Nasıl Korunur? Kalbinizin Dostu Olun
Kalp sağlığı, yaşam kalitesi ve uzunluğu üzerinde büyük bir etkiye sahiptir. Sağlıklı bir kalp yaşam tarzı ile destek...

Stres Yönetimi ve Baş Etme Stratejileri: İpuçları ve Teknikler
Bu makalede, stres yönetimi ve baş etme stratejilerini keşfederek yaşam kalitenizi artırın ve sağlığınızı koruyun.